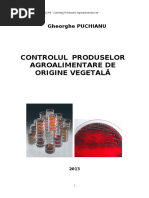

Genul Pseudomonas, Genul Acinetobacter
Genul Pseudomonas
I. Minidefinitie
II. Incadrare taxonomica
III. Habitat
IV. Implicare in patologia umana
V. Microbiologie – principalele caractere si implicatii in patogeneza si
diagnosticul microbiologic
VI. Factori de patogenitate
VII. Patogenie
VIII. Raspunsul imun
IX. Notiuni de epidemiologie si profilaxie a infectiilor nosocomiale
X. Diagnosticul de laborator
Cuvinte cheie: bacili Gram negativi, oxidază pozitivi, aerobi, nefermentativi;
enzime proteolitice, pigmenţi (piocianina, pioverdina, piorubina etc.); miros
aromat; condiţionat patogen, infecţii nosocomiale; hidrofil, psichrotrop; fibroză
chistică, bacteriemii, infecţii urinare, infecţii la arşi; rezistenţă la antibiotice prin
mecanisme multiple: enzime, scăderea permeabilităţii, pompe de eflux,
modificarea ţintei etc.
I. Minidefiniţie
Microorganismele din Genul Pseudomonas sunt bacili Gram negativi, non-
fermentativi (spre deosebire de enterobacterii, care fermentează glucoza), aerobi,
nesporulaţi, care pot fi implicaţi în infecţii cu diverse localizări, la organisme cu
imunitate deficitară.
Este unul dintre patogenii cel mai frecvent implicaţi în infecţiile nosocomiale.
II. Încadrare taxonomică
Domeniu: Bacteria
Phylum: Proteobacteria
Clasa: Gammaproteobacteria
Ordin: Pseudomonadales
Familie: Pseudomonadaceae
Genus: Pseudomonas
Genul Pseudomonas cuprinde un număr mare de specii, dintre care numai unele
au fost izolate de la om. Din acest gen s-au desprins de-a lungul timpului specii înrudite,
dar distincte prin caracterele genetice, cum sunt Burkholderia cepacia,
Stenotrophomonas maltophilia etc.
Pseudomonas aeruginosa este specia cel mai frecvent implicată în infecţii la om.
1
� III. Habitat
Bacteriile din Genul Pseudomonas sunt ubiquitare, putând fi prezente în sol, ape
naturale sau bazine de înot, organisme vegetale şi animale. Majoritatea fac parte din flora
normală, dar pot deveni patogeni condiţionaţi sau oportunişti pentru om, animale sau
plante.
Se remarcă afinitatea microorganismului pentru lichide şi medii umede şi gradul
mare de adaptabilitate, datorită necesităţilor reduse de creştere prin dotarea cu o serie
largă de enzime active pe substraturi nutritive variate.
Colonizează mediul de spital, fiind prezent în aerosoli, apă ditilată contaminată,
soluţii terapeutice - heparina, antiseptice şi/sau soluţii antimicrobiene de clorhexidină,
eozină, polimixina B, săpun lichid etc., pe suprafeţe, echipamente - de aspiraţie, de
dializă, de susţinere respiratorie, termometre, endoscoape -, pe obiecte, inclusiv flori şi
frunze etc.
De semenea, se poate întâlni în bazine de înot, instalaţii sanitare etc.
IV. Implicare in patologia umană
Infecţiile cu Pseudomonas aeruginosa îmbracă forme clinice diferite, în funcţie
de virulenţa microorganismului şi de raspunsul gazdei:
• Infecţii ale pielii (plăgi chirurgicale, arsuri)
• Infecţii de tract urinar, în special nosocomiale, după utilizarea cateterelor urinare
• Infecţii ale tractului respirator inferior: pneumonie de ventilaţie, după asistare
respiratorie în timpul intervenţiei chirurgicale şi/sau resuscitare în secţii de terapie
intensivă, cu diseminare la nivel circulator
• Infecţii respiratorii cronice, în special în maladia congenitală numită fibroză
chistică, în care sunt prezente deficite ale sistemului de apărare locală la nivelul
căilor respiratorii
• Endocardite, meningite, otite, infecţii oculare
• Septicemie - hemoculturile sunt rar pozitive, calea principală de transmitere este
cea limfatică
V. Microbiologie – principalele caractere, implicaţii în patogeneză şi diagnosticul
microbiologic
Prima descriere a bacteriei datează din 1872, când Schroeter îi dă denumirea de
“aeruginosum”, provenind de la aspectul asemănător oxidului de fier.
Datorită elaborării de piocianină, un pigment de culoare albastru-verzui, a fost
denumit bacil piocianic (gr. pios = puroi, cianum = albastru). Puroiul în infecţii cu
Pseudomonas este albastru-verzui
2
� Bacteriile din Genul Pseudomonas sunt bacili Gram negativi, subţiri, drepţi sau
uşor curbaţi (Fig. 1), cu dimensiuni de 0,5-0,8 μm / 1,5-3 μm, care apar izolaţi, în
perechi sau lanţuri scurte. În culturi tinere, putem observa şi forme filamentoase, iar în
culturi îmbătrânite sau pe medii selective, forme de involuţie, ondulate, bacili în formă de
virgulă, coci în lanţuri scurte etc. Sunt nesporulaţi, de obicei necapsulaţi, dar din infecţii
severe s-au izolat şi variante capsulate. Pseudomonas aeruginosa prezintă un singur
flagel situat polar, adică la unul din capete (Fig. 2).
Fig. 1. Frotiu din prelevat cu Pseudomonas aeruginosa
Fig. 2. Pseudomonas aeruginosa – flagel polar
Pseudomonadele cresc foarte uşor, cu foarte puţine surse nutritive, deoarece pot
folosi foarte multe substanţe ca substrat, inclusiv soluţii alcoolice. Cresc pe medii
diferite, chiar nefavorabile, cu substanţe inhibitorii (selective).
Caracterele de cultură pe medii uzuale sunt: dezvoltarea sub formă de colonii
plate, frecvent pigmentate în albastru-verzui, uneori galben (Fig. 3), cu miros aromat
(descris ca miros de tei sau salcâm), datorat producerii de pigmenţi cu structură
fenazinică. Frecvent prezintă un luciu metalic, datorat eliberării de acizi graşi prin liza
substratului nutritiv. Pigmenţii sunt difuzibili în mediu şi sunt de mai multe tipuri:
• piocianina, pigment albastru-verzui, specific pentru Pseudomonas aeruginosa,
care nu apare la nici o altă specie, solubil în cloroform, apă caldă etc.
• pioverdina, fluoresceina, pigment galben-verzui, produs de P. aeruginosa şi alte
specii, insolubil în cloroform, solubil în apă
• eritrina (piorubina), pigment roşu, solubil în apă, insolubil în cloroform, uneori
vizibil doar după extracţia cu cloroform a piocianinei
3
� • piomelanina, pigment negru, apare mai rar
Pigmenţii sunt sintetizati mai bine în anaerobioză. Există şi tulpini acromogene.
Aspectul coloniile diferă în funcţie de mediul pe care sunt cultivate tulpinile de
Pseudomonas aeruginosa:
- pe agar simplu, colonii cu pigment caracteristic, albastru-verzui, care
difuzează în mediu (Fig. 3)
- pe agar sânge : colonii gri, lucioase, cu luciu metalic şi hemoliza de tip β,
mai puternică la temperatura camerei
- pe agar Mac Conkey: colonii mici, lactoză negative, incolore
- pe bulion nutritiv sau apă peptonata 1% tulbură uniform mediul şi
formează văl la suprafaţa mediului; elaborează un pigment gri
- pe mediu semisolid, în tub creşte la suprafaţa, deoarece preferă aerobioza
(fig. 4)
Fig. 3. Aspectul coloniilor de Pseudomonas aeruginosa pe agar simplu
[Link]
Fig. 4. Creşterea P. aeruginosa pe mediu semisolid, în tub
În anaerobioză, P. aeruginosa creşte folosind ca acceptor final de electroni nitraţii,
pe care îi reduce la nitriţi (Fig. 5).
4
� Fig. 4. P. aeruginosa reduce nitraţii la nitriţi
Pseudomonadele sunt catalază şi oxidază pozitivi (Fig. 5).
Fig. 5. [Link]ţie pentru catalază pozitivă – efervescenţă în apă oxigenată;
b. Reacţie pentru oxidază pozitivă – metoda cu disc impregnat cu reactiv
pentru oxidază
a. b.
[Link]
5
� VI. Factori de patogenitate
Factorii de patogenitate ai P. aeruginosa sunt structuri somatice sau produse
extracelulare.
Dintre structurile somatice cu rol în patogenitate fac parte capsula polizaharidică,
pilii, flagelul, lipopolizaharidul, acesta din urmă cu activitate endotoxinică.
P. aeruginosa eliberează enzime, cum sunt: neuraminidaza, care favorizează
aderenţa la celulele gazdei, proteaze alcaline, elastaze, hemolizine cu activitatea de
lecitinaea, fosfolipaze etc. şi toxine, ca: exotoxina A, exotoxina E, piocianina, care
mediază leziunile tisulare. Exotoxina A, specifica pentru P. aeruginosa, actionează
asemănător cu toxina difterică.
Rezistenţa la un număr mare de clase de antibiotice constituie adesea un factor
suplimentar de patogenitate la P. aeruginosa, mai ales în infecţiile nosocomiale.
VII. Patogenie
Etapele instalării infecţiei cu P. aeruginosa sunt:
- aderenţa la celulele endoteliale, cu ajutorul pililor şi proteinelor implicate în
aderenţă
- persistenţa la nivel local prin intermediul materialului exopolizaharidic, cu
structură de alginat, care face posibilă formarea unui biofilm cu protejarea bacteriei faţă
de factorii de apărare locali, antibiotice etc.
- efecte locale prin exotoxina A, care inhibă sinteza proteică, prin mecanism
asemănător toxinei difterice, fosfolipaze cu efect hemolitic şi de degradare a
surfactantului pulmonar, elastaze care degradează proteinele matricei extracelulare şi Ig
G etc. Aceste enzime joacă un rol important în invazie şi distrucţia celulară, la nivel
pulmonar şi/sau în alte zone anatomice (cornee, alte ţesuturi invadate etc.). Pigmenţii şi
alţi compuşi cu fier cauzează leziuni entoteliale caracteristice infecţiei cu P. aeruginosa
- efecte generalizate, în infecţii sistemice, prin endotoxina capabilă de a declanşa
şocul septic
VIII. Răspunsul imun
Imunitatea în infecţiile cu P. aeruginosa este naturală şi/sau câştigată.
Imunitatea naturală este reprezentată de integritatea pielii/mucoaselor, intervenţia
celulelor fagocitare, a sistemului complement etc.
Imunitatea câţtigată este humorala (Ac antitoxici, Ac antibacterieni - Ig G anti
„O”, anti-endotoxinice, tip specifice) şi celulară (limfocite T).
IX. Noţiuni de epidemiologie şi profilaxie a infecţiilor nosocomiale
6
� Infecţie nosocomială sau infecţie spitalicească este considerată orice infecţie
câştigată de un pacient internat sau care primeţte îngrijiri în ambulator, care devine
manifestă în timpul internării (după cel puţin 48 h de la internare) sau după externare (ex.
la câteva luni după inserţia unei proteze).
Infecţiile nosocomiale au multiple consecinţe medicale, etice, economice, legale
etc.
Principalele categorii de microorganisme implicate în etiologia infecţiilor
nosocomiale sunt:
- bacilii Gram negativi: Pseudomonas, Klebsiella, Acinetobacter etc. – pana
la 60% din infecţiile nosocomiale
- cocii Gram pozitivi: Staphylococcus, Enterococcus, Streptococcus etc.
- fungii: Candida albicans etc.
Pseudomonas aeruginosa este bacilul Gram negativ cel mai frecvent implicat în
etiologia infeţiilor nosocomiale, provenind din surse exterioare spitalului (aer, suprafeţe,
surse de apă) sau surse din spital (pacienţi cu infecţii, purtători - aproximativ 10% din
oameni poartă P. aeruginosa în colon), diferite echipamente contaminate.
Cei mai expuşi sunt indivizii care prezintă factori de risc, cum sunt:
• Investigaţii exploratorii moderne si/sau tratamente care afectează integritatea
pielii şi mucoaselor: abord arterial, uretral, cateterisme, intubaţii, bronhoscopii
etc.; în aceste situaţii, foarte importantă este respectarea procedurilor
investigaţionale, respectiv spălarea corectă a mânilor, schimbarea echipamentului
de protecţie între proceduri, existenţa unor echipe distincte de personal afectate
îngrijirii pacienţilor septici şi aseptici etc.
• Imaturitatea sau deprimarea sistemului imunitar: nou născuţi distrofici, pacienţi cu
afecţiuni coexistente internaţi în servicii de hematologie, oncologie, urologie,
reanimare şi terapie intensivă etc., cu neoplasme, tuberculoză, SIDA, arsuri,
politraumatisme etc., pacienţi imunosupresaţi prin tratamente cu citostatice,
radioterapie etc.
• Utilizarea neadecvată a antibioticelor, care contribuie la selecţia de tulpini
rezistente şi favorizează autoinfecţia prin suprimarea florei normale. Greşelile pot
consta în: nerespectarea ordinii de administrare a antibioticelor, nerespectarea
duratei de administrare (scurtare sau prelungire), nerespectarea dozelor,
nerespectarea politicii de administrare a antibioticelor, rezultate din datele
cumulative ale rezistenţei la antibiotice prezentate de laboratorul de microbiologie
etc.
Sursele patogenilor nosocomiali sunt elucidate doar în doua treimi dintre cazuri:
• Translocare (schimbarea situsului unor bacterii care colonizează
normal organismul, cu invadarea unor situsuri anatomice normal
sterile), de exemplu la pacientii aplastici (8%),
• Surse de infecţie digestive (10%)
• Surse cutanate, în cazul dispozitivelor intravasculare (33,6%) –
Fig. 6
• Surse urinare (16%) – infecţii urinare, mai ales după cateterizare
urinară
• Surse respiratorii (Fig. 7)
7
� Cei mai expuşi sunt pacienţii cu fibroză chistică, arşii şi pacienţii cu neoplasme,
care rămân internaţi pentru perioade lungi de timp în unităţi de îngrijire medicală.
8
�Fig. 6. Surse de infecţie în cazul dispozitivelor intravasculare
Fig. 7. Sursa de infecţie respiratorie – aparat de ventilaţie mecanică
În cazul infecţiilor cu Pseudomonas aeruginosa au fost utilizate vaccinuri
piocianice polivalente, în scop profilactic şi/sau terapeutic sau vaccinuri monovalente, în
scop terapeutic.
Profilaxia nespecifică constă în curăţirea şi dezinfecţia mediului spitalicesc,
educarea periodică a personalului, controlul şi monitorizarea purtătorilor, evitarea
contaminării, utilizarea antisepticelor şi dezinfectantelor, în funcţie de rezultatele testării
sensibilităţii etc.
X. Diagnosticul de laborator
Diagnosticul infecţiilor cu Pseudomonas aeruginosa este exclusiv bacteriologic.
Etapele diagnosticului sunt următoarele:etape:
1. Prelevarea, transportul şi pregătirea probelor
2. Examenul microscopic direct pentru: spută, LCR, lichide de puncţie,
aspirate traheale
3. Izolarea – se face prin inoculare directă pe agar-sânge, mediu Mc Conkey
sau alte medii diferenţiale şi prin îmbogăţire în apă peptonată 1%, când se
9
� anticipeazî prelevate cu un număr mic de bacterii sau bulion cu TTC
(tripheniltetrazolium chloride 1%), care inhibă microorganismele asociate
în prelevate presupus pluricontaminate
4. Identificarea se face prin:
- microscopie: bacili Gram negativi
- aspectul pe agar sânge: β- hemolitic, colonii S, mai rar R, luciu metalic,
miros aromatic
- aspectul pe medii care susţin producerea de pigment King A (sau King P)
pentru piocianină, King B (sau King F) pentru fluoresceină
- aspectul pe apă peptonată 1% - văl la suprafaţă, uneori pigment
- aspectul pe medii cu TTC 1% - colonii roşu închis
5. Detectarea unor markeri microbiologici de interes epidemiologic:
serogrup, lizotip, pattern molecular etc.
6. Testarea sensibilităţii la antibiotice – permite detectarea unor fenotipuri de
rezistenţă complexe, deseori cu rezistenţă multiplă la beta-lactamine,
aminoglicozide, quinolone etc.
Genul Acinetobacter
I. Minidefinitie
II. Incadrare taxonomica
III. Habitat
IV. Implicare in patologia umana
V. Microbiologie – principalele caractere si implicatii in patogeneza si
diagnosticul microbiologic
VI. Factori de patogenitate
VII. Patogenie
VIII. Raspunsul imun
IX. Notiuni de epidemiologie si profilaxie a infectiilor nosocomiale
X. Diagnosticul de laborator
Cuvinte cheie: cocobacili gram negativi, nefermentativi, oxidază negativi, catalază
pozitivi; infecţii asociate îngrijirilor medicale, infecţii în mediul extraspitalicesc
I. Minidefiniţie
Cocobacili Gram negativi, nefermentativi, nesporulaţi, imobili, strict aerobi,
catalază pozitivi, oxidază negativi, pot fi implicaţi în patologia umană ca microorganisme
oportuniste. Frecvent implicaţi în infecţii nosocomiale.
II. Incadrare taxonomică
Domeniu: Bacteria;
10
�Phylum: Proteobacteria;
Clasa: Gammaproteobacteria;
Ordin: Pseudomonadales;
Familie: Moraxellaceae
Gen: Acinetobacter
Cuprinde peste 30 specii diferenţiate prin metode genetice. Specii mai
frecvent implicate sunt: Acinetobacter baumannii, Acinetobacter calcoaceticus,
facând parte din complexul Acb (Acinetobacter calcoaceticus - A. baumanii)
III. Habitat
Ubiquitar, se găseşte în sol, surse de apă, pe suprafeţe uscate, pe suprafaţa
alimentelor, iar în mediul de spital, pe suprafeţe, instrumentar medical etc.
Poate coloniza organisme vii, cu sau fără manifestări de natură infecţioasă,
Portajul cutanat sau gastrointestinal este de până la 25% la indivizi sănătoşi.
La pacienţi spitalizaţi pentru perioade mai lungi de timp pot coloniza tractul
respirator.
IV. Implicare în patologia umană
Cauzează infecţii la pacienţi care prezintă factori de risc, în special internaţi în
spital, în secţii ca reanimarea şi terapia intensivă, oncologie, arşi etc.
Principalele afecţiuni cauzate de Acinetobacter sunt: pneumonie, meningită,
septicemie, infecţii gastrointestinale, infecţii de tract urinar, infecţii de plagă.
În ambulator poate să cauzeze pneumonii şi infecţii de plagă.
V. Microbiologie – principalele caractere, implicaţii în patogeneză şi diagnosticul
microbiologic
Bacteriile din Genul Acinetobacter, familia Moraxellaceae sunt cocobacili Gram
negativi, cu dimensiuni de 1.0-1.5/1.5-2.5 , imobili, nesporulaţi, catalază pozitivi,
oxidază negativi, strict aerobi.
Aspectul pe frotiu este de cocobacili rezistenţi la decolorare, în perechi sau
grupaţi în grămezi, cu variaţii de dimensiune şi colorabilitate, iar în culturi vechi iau
forme cocoide.
Pe mediile de cultură se dezvoltă sub forma coloniilor incolore, galben pal sau gri,
uneori mucoide. Unele tulpini pot fi hemolitice pe agar sânge.
Folosesc diferite substanţe organice ca sursă de carbon.
11
� VI. Factori de patogenitate
Deşi nu este considerat un microorganism cu grad înalt de
patogenitate, Acinetobacter posedă factori de patogenitate cum sunt:
capsula, fimbriile implicate în aderenţă, enzime cu activitate lipolitică,
lipopolizaharidul, sideroforii, proteine ale membranei externe cu rol în
aderenţă etc.
VII. Patogenie
La pacienţii cu factori de risc (după chirurgie majoră, cu
neoplazii, arsuri, vârste extreme, tratamente îndelungate cu
antibiotice, boli pulmonare cronice, tratament cu imunosupresoare,
dispozitive protetice endotraheale, gastrice etc.), bacteria provenită
din flora endogenă sau din mediul exterior poate determina manifestări
patologice de natură infecţioasă, cu exacerbarea virulenţei, creşterea
hidrofobicităţii tulpinilor la nivelul suprafeţelor dispozitivelor etc.
VIII. Răspunsul imun
Imunitatea este de tip umoral şi celular. Mai multe antigene, între care proteinele
membranei externe sunt implicate în stimularea răspunsului imun, astfel că au fost
încercate vaccinuri preparate din acestea, cu bune rezultate la pacienţii cu risc înalt.
IX. Noţiuni de epidemiologie şi profilaxie a infecţiilor nosocomiale
Infecţiile apar mai frecvent în sezonul cald, dar pot surveni în
oricare perioadă a anului.
Situsurile anatomice de colonizare la indivizi sănătoşi sunt cele
cu umiditate crescută, aşa cum întâlnim la nivelul axilelor, zonei
inghinale, spaţiilor interdigitale etc.; cel puţin 25% din populaţia
normală este purtătoare, iar în spital procentul purtătorilor este mai
mare, în special la pacienţi care sunt asistaţi ventilator.
X. Diagnosticul de laborator
Prelevatele pot fi însămânţate pe medii simple, ca agarul nutritiv
simplu sau agar tripticase soya sau pe medii cu compoziţie controlată
în nutrienţi şi săruri minerale. Pentru izolare din prelevate
pluricontaminate se utilizează medii cu adaos selectiv de antibiotice şi/
sau bilă.
Există specii care cresc la temperaturi mai joase decât 37 0 C.
12
� Identificarea se face pe baza caracterelor microscopice, de
cultură şi metabolice.
Identificarea de certitudine se face prin metode moleculare
bazate pe hibridizarea ADN.
Pentru tipizarea în scopuri epidemiologice se poate utilize
ribotipia, analiza cu enzime de restricţie etc.
Este necesară testarea sensibilităţii la antibiotice, având în
vedere existenţa fenotipurilor cu rezistenţă multiplă, mai ale în mediul
de spital.
Tratamentul empiric se face cu monoterapie în infecţii urinare, cu
asocieri β-lactamine-aminoglicozide în pneumone şi septicemia şi cu
tigeciclină în cazul tulpinilor cu rezistenţă multiplă.
13